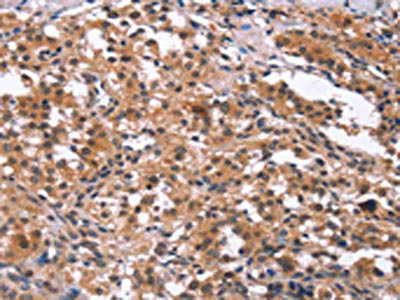

GCKR Antibody
-
中文名稱:GCKR兔多克隆抗體
-
貨號:CSB-PA287752
-
規格:¥1100
-
圖片:
-
The image on the left is immunohistochemistry of paraffin-embedded Human thyroid cancer tissue using CSB-PA287752(GCKR Antibody) at dilution 1/15, on the right is treated with synthetic peptide. (Original magnification: ×200)
-
The image on the left is immunohistochemistry of paraffin-embedded Human brain tissue using CSB-PA287752(GCKR Antibody) at dilution 1/15, on the right is treated with synthetic peptide. (Original magnification: ×200)
-
-
其他:
產品詳情
-
Uniprot No.:
-
基因名:GCKR
-
別名:FGQTL5 antibody; GCK antibody; GCKR antibody; GCKR_HUMAN antibody; GKRP antibody; GLRE antibody; glucokinase (hexokinase 4) regulator antibody; Glucokinase antibody; Glucokinase regulator antibody; Glucokinase regulatory protein antibody; Hexokinase 4 regulator antibody; Hexokinase type IV antibody; Hexokinase-4 antibody; Hexokinase-D antibody; HK IV antibody; HK4 antibody; OTTHUMP00000158533 antibody
-
宿主:Rabbit
-
反應種屬:Human,Mouse,Rat
-
免疫原:Synthetic peptide of Human GCKR
-
免疫原種屬:Homo sapiens (Human)
-
標記方式:Non-conjugated
-
抗體亞型:IgG
-
純化方式:Antigen affinity purification
-
濃度:It differs from different batches. Please contact us to confirm it.
-
保存緩沖液:-20°C, pH7.4 PBS, 0.05% NaN3, 40% Glycerol
-
產品提供形式:Liquid
-
應用范圍:ELISA,IHC
-
推薦稀釋比:
Application Recommended Dilution ELISA 1:1000-1:2000 IHC 1:25-1:100 -
Protocols:
-
儲存條件:Upon receipt, store at -20°C or -80°C. Avoid repeated freeze.
-
貨期:Basically, we can dispatch the products out in 1-3 working days after receiving your orders. Delivery time maybe differs from different purchasing way or location, please kindly consult your local distributors for specific delivery time.
-
用途:For Research Use Only. Not for use in diagnostic or therapeutic procedures.
相關產品
靶點詳情
-
功能:Regulates glucokinase (GCK) by forming an inactive complex with this enzyme. Acts by promoting GCK recruitment to the nucleus, possibly to provide a reserve of GCK that can be quickly released in the cytoplasm after a meal. The affinity of GCKR for GCK is modulated by fructose metabolites: GCKR with bound fructose 6-phosphate has increased affinity for GCK, while GCKR with bound fructose 1-phosphate has strongly decreased affinity for GCK and does not inhibit GCK activity.
-
基因功能參考文獻:
- The results suggest that the GCKR and G6PC2 genes may contribute to the risk of type 2 diabetes independently and/or in an interactive manner in the Han Chinese population. PMID: 30055620
- Results show that GCKR was associated with hypertriglyceridemia in Mexican Mestizos but not in Mexican Amerindians. PMID: 30176313
- The results of this population-based study provide evidence for a relationship between lipid regulatory gene polymorphisms including GCKR (rs780094), GCKR (rs1260333), FADS (rs174547), and MLXIPL (rs3812316) with dyslipidemia in an Iranian population. PMID: 29858861
- genome-wide association study in US: Data suggest, among white subjects, an SNP in RCN3 (rs34459162) and a missense mutation in GCKR (rs1260236) are associated with serum levels of glycated albumin; among black subjects, an intergenic SNP in PRKCA (rs2438321) is associated with fructosamine levels and an intronic variant in PRKCA (rs59443763) is associated with glycated albumin levels. (RCN3 = reticulocalbin-3) PMID: 29844224
- Interaction of any alcohol exposure with GCKR (rs780094) and A1CF (rs10821905) influenced the risk of gout in Europeans PMID: 28679452
- GCKR rs780094-C is associated with increased risk of gestational diabetes mellitus.[meta-analysis] PMID: 29410004
- Mutations in the genes glucokinase regulatory protein (GCKR), RNase L (RNASEL), leukocyte immunoglobulin-like receptor 3 (LILRA3), and dynein axonemal heavy chain 10 (DNAH10) segregated with elevated HDLc levels in families, while no mutations associated with low HDLc. PMID: 24891332
- rs1260326 T-allele was associated with plasma lactate in European-Americans and African-Americans. PMID: 26433129
- Patients with moderately controlled type 2 diabetes carrying two T alleles displayed higher plasma triglycerides levels than homozygous carriers of the C allele, whereas no differences were observed in healthy individuals. PMID: 27660121
- GCKR association with adiposity and the risk of the nonalcoholic fatty liver disease PMID: 28436986
- The existence of a liver-specific FOXA2-regulated transcriptional enhancer at an intronic T2D locus represented by rs780094, rs780095, and rs780096 SNPs that increases GCKR expression is demonstrated. PMID: 28683826
- GCKR Leu446 may influence FGF21 expression via its ability to increase glucokinase (GCK) activity. This can lead to enhanced FGF21 expression via elevated fatty acid synthesis, consequent to the inhibition of carnitine/palmitoyl-transferase by malonyl-CoA, and via increased glucose-6-phosphate-mediated activation of the carbohydrate response element binding protein, known to regulate FGF21 gene expression. PMID: 28385800
- The rs780094 [1.34 (1.21-1.49); p = 8.57 x 10(-8) ] on chr 2 at the glucokinase regulatory protein (GCKR) locus was similarly significantly associated, while the rs10911205 [1.29 (1.16-1.44); p = 3.52 x 10(-6) ] on chr1 at the laminin subunit gamma-1 (LAMC1) locus showed suggestive association with disease. PMID: 27599772
- Carriers of the C allele of rs780094 were 1.41 (odds ratio, 95% CI, 0.97-2.03) times more likely to develop Gestational Diabetes. PMID: 27554451
- Among Mexicans, the PNPLA3 (rs738409), LYPLAL1 (rs12137855), PPP1R3B (rs4240624), and GCKR (rs780094) polymorphisms may be associated with a greater risk of chronic liver disease among overweight adults. PMID: 27752939
- The present study explored the association between a common variant of the glucokinase regulator (GCKR) gene and metabolic syndrome and its related traits in Taiwanese adolescents PMID: 26799416
- This study shows that in patients with type 2 diabetes who were not selected for liver abnormalities, liver fat content was related to GCKR rs1260326 polymorphism PMID: 25976242
- Lifestyle Intervention for Weight Loss and Cardiometabolic Changes in the Setting of Glucokinase Regulatory Protein Inhibition: Glucokinase Regulatory Protein-Leu446Pro Variant in Look AHEAD PMID: 26578543
- The GCKR rs780092 variant showed opposite-directional associations with type 2 diabetes and hypertriacylglycerolaemia in a Chinese population. PMID: 26515422
- The AA genotype of the GCKR rs780094 polymorphism may increase the risk of T2D among ethnic Uygurs from Xinjiang. PMID: 27455017
- Two new polymorphisms associated with gall bladder disease and obesity in women have been identified, GCKR rs1260326, and TTC39B rs686030. PMID: 25920552
- We found that the PPARGC1A and PNPLA3 variants, but not the GCKR variant, were associated with NASH. PMID: 27015186
- Disruption of the GKRP-glucokinase complex is a promising new antidiabetic target, since it results in lower plasma glucose levels without inducing hypoglycemia[review] PMID: 26432016
- this is the first evidence that n-3 LC-PUFAs may modulate the impact of the GCKR rs1260326 polymorphism on TG concentrations in adolescents. Several molecular mechanisms, in link with glucose uptake, could explain these findings PMID: 26136510
- SNPs in SORT1, CETP and GCKR were individually associated with lipid level variations in Algerian population. PMID: 26261636
- interaction effects between GCKR genetic variants and the dietary MUFA:SFA ratio on lipid levels PMID: 26291577
- rs1260326 in GCKR significantly associates with alpha-1 antitrypsin levels. PMID: 26174136
- GCKR polymorphisms might be independent predictors of survival in metastatic gastric cancer patients treated with first-line EOF chemotherapy PMID: 26115082
- The AA genotype in maternal GCKR rs780094 is associated with an increased risk for neural tube defects and spina bifida in the Chinese population. PMID: 25369983
- Single-nucleotide polymorphisms alleles near GCKR that were associated with higher coffee consumption. PMID: 25288136
- GCKR variants across the allelic spectrum have effects on glucose and lipid homeostasis. [Review] PMID: 25692341
- GCKR rs1260326 gene variant, which is associated with greater glycolysis, increases hepatic De Novo Lipogenesis. PMID: 26043229
- Polymorphisms in GCKR, SLC17A1 and SLC22A12 were associated with phenotype gout in Han Chinese males. PMID: 26290326
- meta-analysis provides evidence of significant association between GCKR rs780094 and risk of nonalcoholic fatty liver disease PMID: 25167786
- GCKR rs780094 variants modulate uric acid concentrations in Chinese males. PMID: 25283508
- Individuals who are homozygous TT at rs1260326 of the GCKR gene have higher triglyceride, total and LDL cholesterol levels regardless of the presence of GCK mutations. PMID: 24918535
- Despite evidence for their collective functional and clinical relevance, results emphasize the low predictive value of rare GCKR variants in individuals and the complex heritability of lipid traits. PMID: 24879641
- genetic association studies in Japan: Data suggest that SNPs in GCKR (rs780094), TRIB1 (tribbles pseudokinase 1, rs2954021), and PNPLA3 (patatin-like phospholipase domain containing 3, rs738409) are associated with nonalcoholic fatty liver disease. PMID: 24785259
- Results showed that the GCKR rs1260326 polymorphism is significantly associated with the risk of chronic kidney disease (CKD) in Japanese individuals, and found a possible significant interaction between this polymorphism and current smoking on CKD risk. PMID: 24535998
- GCKR and PNPLA3 genes interact to result in increased susceptibility to NAFLD. PMID: 23800943
- Data indicate that in non-alcoholic fatty liver disease (NAFLD), glucokinase regulatory protein (GCKR) rs780094 C>T is associated with the severity of liver fibrosis and with higher serum triglyceride levels. PMID: 24498332
- GCKR rs780094 was associated with TG, HDL-C, and HbA1c levels, as well as with CIMT in Japanese community-dwelling men. PMID: 23989113
- genetic association studies in population in Norfolk, England: Data suggest that an SNP in GCKR (rs780094) is associated with risk of cardiometabolic diseases (cardiovascular diseases; diabetes type 2) in the population studied. PMID: 24804806
- genetic polymorphism is associated with Factor VII and with plasma viscosity PMID: 24178511
- The GCKR rs780093 polymorphism is a risk factor for coronary heart disease in individuals aged 65 and older. PMID: 24385677
- RESULTS: rs1260326 in GCKR (beta=1.30, P = 3.23E-03), rs17319721 in SHROOM3 (beta = -1.28, P-value = 3.18E-03) and rs12917707 in UMOD (beta = 2.0, P-value = 8.84E-04) were significantly associated with baseline estimated GFR PMID: 23586973
- genetic association studies in Han Chinese population in Taiwan: Data suggest that an SNP in GCKR (rs780094) is associated with increased susceptibility/risk of nonalcoholic fatty liver disease in the population of obese children studied. PMID: 24477042
- Findings from middle-aged to older adults confirm associations between rs1260326 GCKR and triglycerides and glucose, suggest gene-environment interactions, but do not provide evidence that its relevance extends to cognitive and physical capability. PMID: 23894584
- Some, but not all, associations between variants in NCAN, lysophospholipase-like 1, GCKR, and PPP1R3B with hepatic steatosis (with and without increased ALT level) were significant within subpopulations. PMID: 23416328
- Our observations provide a model for the regulation of GCK-GKRP complex stability by sugar phosphates involving a subtle reorganization of the GKRP scaffold. PMID: 23957911
顯示更多
收起更多
-
亞細胞定位:Cytoplasm. Nucleus. Mitochondrion.
-
蛋白家族:GCKR family
-
組織特異性:Found in liver and pancreas. Not detected in muscle, brain, heart, thymus, intestine, uterus, adipose tissue, kidney, adrenal, lung or spleen.
-
數據庫鏈接:
Most popular with customers
-
-
YWHAB Recombinant Monoclonal Antibody
Applications: ELISA, WB, IHC, IF, FC
Species Reactivity: Human, Mouse, Rat
-
Phospho-YAP1 (S127) Recombinant Monoclonal Antibody
Applications: ELISA, WB, IHC
Species Reactivity: Human
-
-
-
-
-